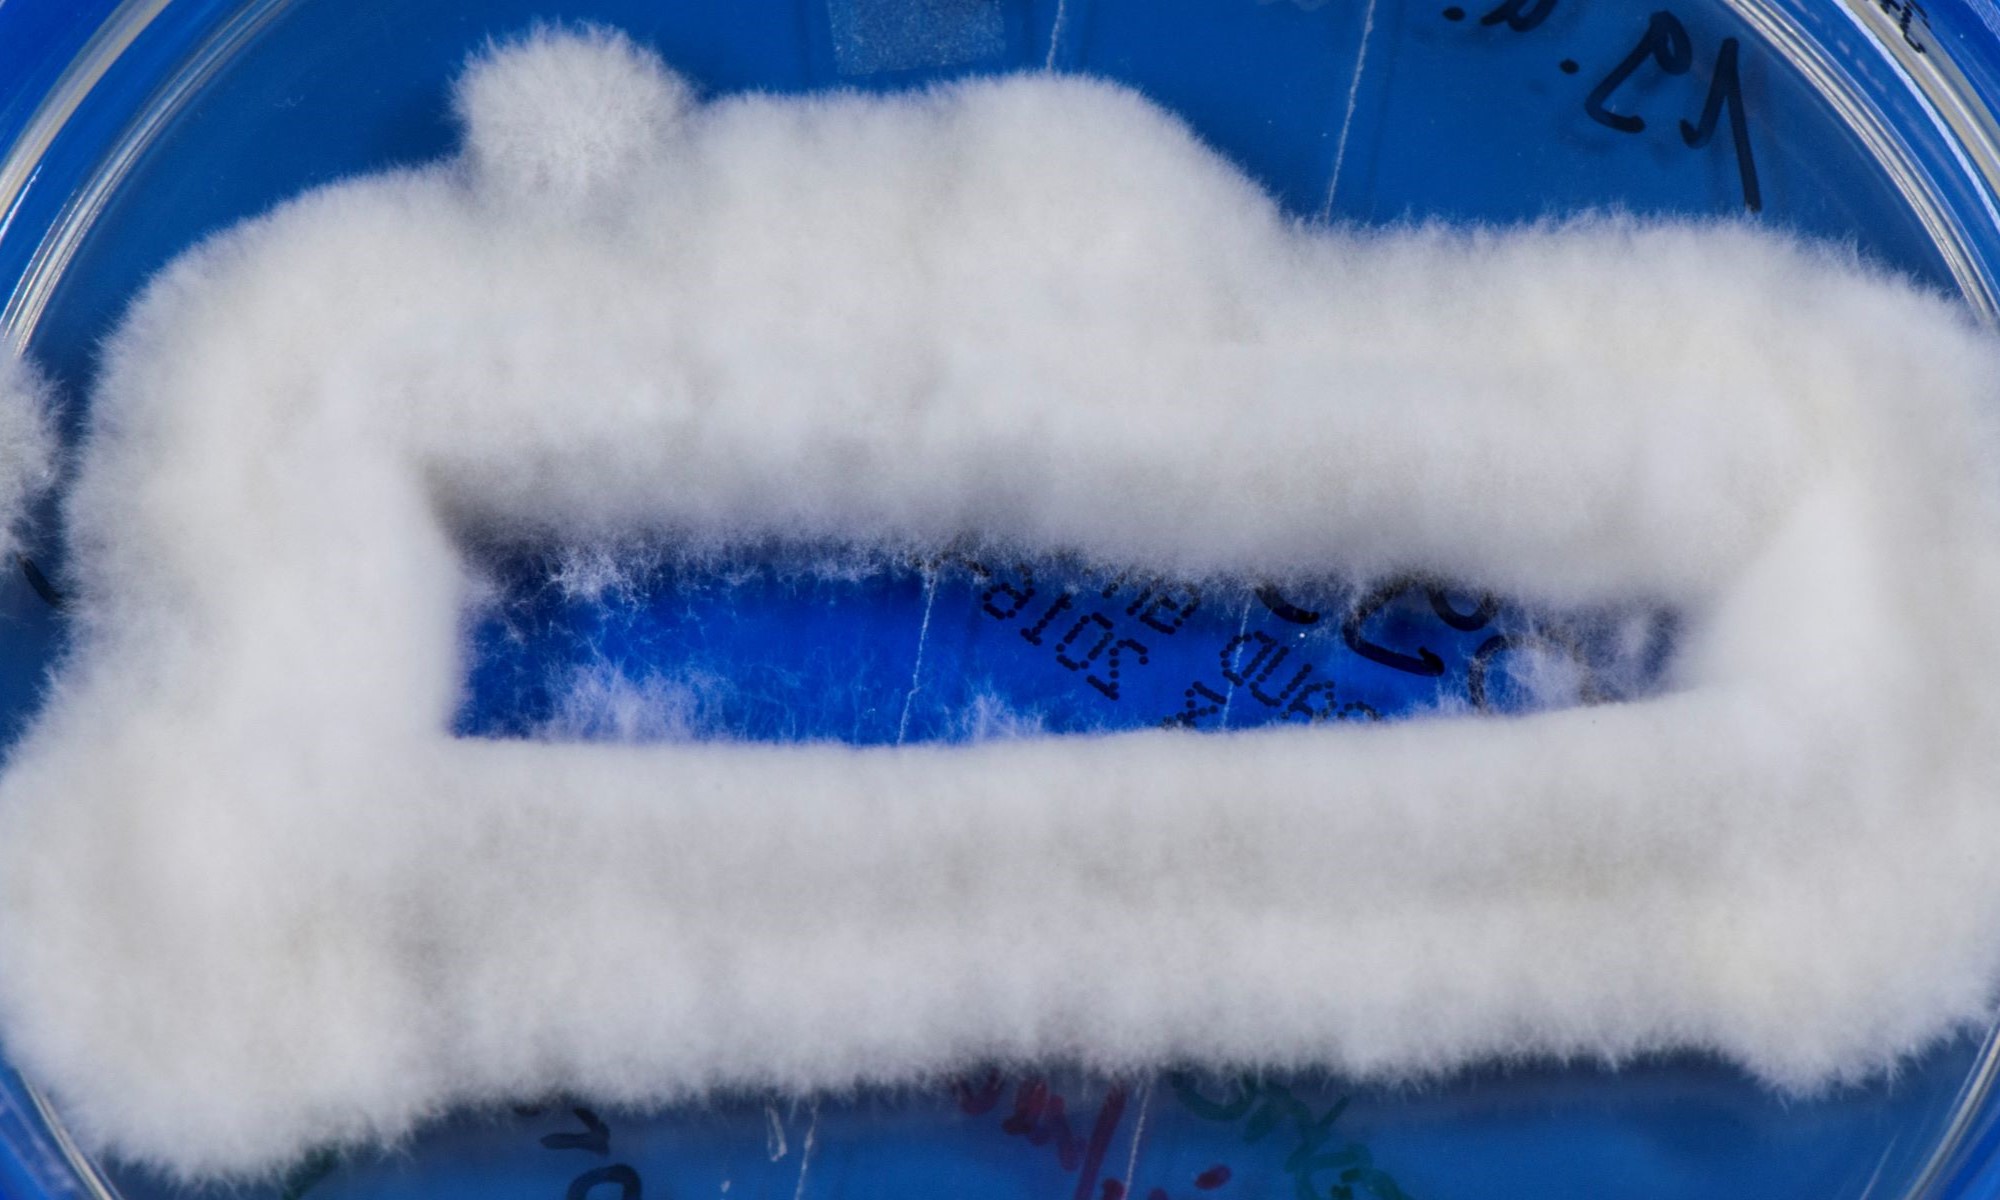
LABOPART Arthroderma quadrifidum

The Arthrodermataceae are a family of fungi containing nine dermatophyte genera — Epidermophyton, Microsporum, Nannizzia, Trichophyton, Paraphyton, Lophophyton, Guarromyces, Ctenomyces and Arthroderma.
References
External links
- Trichophyton spp. at Doctor Fungus
- Mycology Unit at the Adelaide Women's and Children's Hospital
- Arthrodermataceae at the U.S. National Library of Medicine Medical Subject Headings (MeSH)